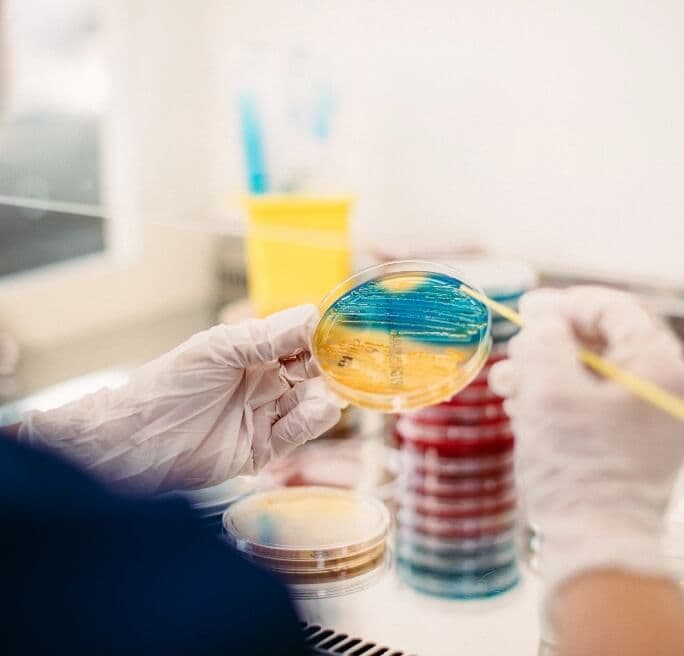
Am derulat controale externe de calitate încă din anul 2000

Un laborator de analize medicale cu suflet
Ghidați de performanță, curaj, empatie și implicare, le oferim pacienților noștri servicii de laborator de înaltă calitate, dar și multă grijă. Cu fiecare analizor achiziționat, alături de fiecare om pe care îl pregătim și prin fiecare minut petrecut în laborator, ne asigurăm că ai parte de rezultate sigure și de suportul pe care îl meriți.
Din 1992 până în prezent
Povestea Bioclinica* a început în anul 1992, în Timișoara, atunci când actualul director general, alături de alți trei profesioniști, a deschis primul laborator de analize medicale Biomedica. Împreună au pus bazele a ceea ce avea să devină un standard în ceea ce privește serviciile clinice de laborator.
Nu a durat mult și, în 1997, am deschis un nou laborator la Arad. Chiar dacă drumul a fost pavat cu multe obstacole, am reușit să le depășim pentru a menține standardele înalte de calitate pentru analizele oferite. Mai mult, suntem mândri că am fost printre pionierii sistemului privat în România.
Credem că atât timp cât investim pasiune în ceea ce facem și abordăm totul cu profesionalism, drumul către succes ne este asigurat. Și pentru că am considerat că putem fi mai aproape de pacienții noștri cu un nume care ne definește mai bine, în 1998, am hotărât să ne schimbăm numele în Bioclinica.
Contactează-ne

Extindere la nivel național
Și așa, Bioclinica și-a început activitatea. De la schimbarea numelui, am crescut și ne-am extins, iar acum, sub cupola unui grup de societăți, Bioclinica numără la nivel național 15 laboratoare și 176+ puncte de recoltare proprii, având și suportul unei rețele de 100+ colaboratori în toată țara.
În cele 176+ puncte de recoltare pot fi efectuate peste 2700 investigaţii de laborator, iar acestea sunt situate în toată România în următoarele județe: Alba, Arad, Argeș, Bacău, Bihor, Bistrița-Năsăud, Brăila, Brașov, București, Buzău, Călărași, Caraș Severin, Cluj, Constanța, Covasna, Dâmbovița, Dolj, Gorj, Harghita, Hunedoara, Ialomița, Iași, Maramureș, Mehedinți, Mureș, Neamț, Olt, Prahova, Sălaj, Satu Mare, Sibiu, Suceava, Timiș, Tulcea și Vâlcea. Accesibilitatea este foarte importantă pentru noi și de aceea, chiar dacă există județe în care nu avem încă laboratoare deschise, am suplimentat zonele cu mai multe puncte de recoltare.
Toate locațiile

Laboratoare cu dotări moderne
Drumul nostru nu se oprește aici. Ne dorim să ne dezvoltăm continuu, pentru a putea oferi o gamă cât mai largă de analize. Credem în performanță și investim în aparatură și tehnologii moderne, în personal bine pregătit și în tehnici de lucru ce respectă standarde înalte. Toate acestea ne oferă calitate și viteză în prelucrarea analizelor.
Pentru a confirma calitatea serviciilor noastre, am derulat controale externe de calitate încă din anul 2000, sub egida unor foruri recunoscute atât pe plan național, cât și internațional: INSTAND e.V. (Germania), EQAS (S.U.A.), RIQAS (Irlanda), NEQAS (Marea Britanie), HEMATROM (România). Controalele de calitate pentru fiecare analizator în parte sunt efectuate zilnic pentru a asigura funcționarea acestora în parametri optimi.
Află mai multe
Peste 2700 analize medicale
Calitatea pe care o oferim pacienților noștri este esențială, dar mai mult decât atât, ne dorim să vă ajutăm și să vă fim aproape în problemele pe care le întâmpinați. Credem în umanitate și în binele pe care îl aducem în viețile pacienților noștri. Pentru voi, cerem mai mult de la noi în fiecare zi și cu determinare și consecvență, ne dezvoltăm pentru a oferi analize cu suflet.
Pacienții noștri merită tot ce e mai bun și vom face tot posibilul să vă oferim rezultate pe care vă puteți baza. Pentru voi, pacienții noștri, în colaborare cu laboratorul Dr. Limbach, Ganzimmun (Germania) și Reference Laboratory (Spania) am extins gama de analize medicale la un număr de peste 2700, care acoperă domenii variate: hematologie, biochimie, imunologie, microbiologie, alergologie, biologie moleculară, toxicologie, anatomie patologică și genetică moleculară.
Toate analizele

Echipă de profesioniști cu suflet
Știm că nu întâlnești des în viață și performanța și empatie. Noi ne străduim să fim un exemplu în acest sens și să oferim pacienților noștri mai mult decât profesionalism rigid. Ne dorim ca pacienții noștri să știe că ne pasă.
Echipa noastră de profesioniști este cea care aduce suflet în laboratoare. Medicii, biologii chimiștii și biochimiștii noștri sunt aici să îți ofere ajutorul de care ai nevoie. Ei sunt cei care fac bine comunității prin pasiune, integritate, asumare și conștiinciozitate. Zi de zi, pentru oameni.
Laboratoarele (Arad, Bistrița, Brașov, București, Cluj-Napoca, Constanța, Craiova, Deva, Iași, Oradea, Târgu Jiu, Târgu Mureș, Timișoara) sunt acreditate conform standardului SR EN ISO 15189:2013 și sunt în relație contractuală cu Casa de Asigurări de Sănătate (CAS).
*Strategiile de promovare și marketing (online și offline) pentru serviciile prestate de laboratoarele și punctele de recoltare Bioclinica din toată țara sunt adoptate la nivelul conducerii Grupului Bioclinica și sunt în acord cu politicile intragrup relevante.






